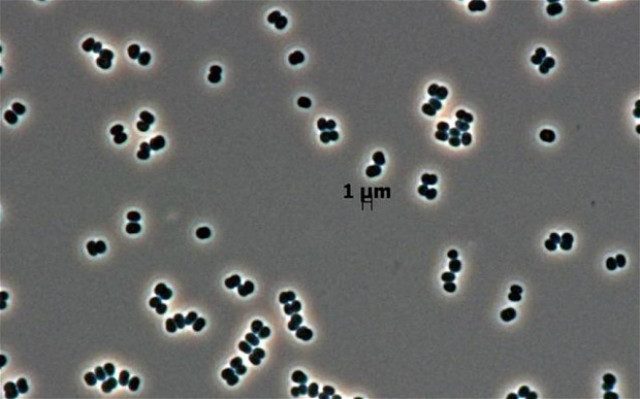

Удивительные факты о космонавтике. Класс!
Шикарный пост, вам понравится!
Кадры кинохроники запечатлели встречу Гагарина после первого космического полёта в Москве, а больше всего многим запомнился его развязавшийся шнурок. На самом деле эта тесёмка была отцепившейся подтяжкой для носков, которые раньше делали без резинки.
Из-за сползшего носка Гагарина по ноге больно била пряжка, но он не остановился и дошагал по дорожке до конца.

Космонавт Юрий Маленченко незадолго до полёта на МКС в 2003 году сделал предложение американке российского происхождения Екатерине Дмитриевой, мать которой работала в НАСА.
Находясь на станции, он получил уведомление из Центра управления полётами, что его миссия продлевается на несколько месяцев. Молодожёны решили не дожидаться возвращения жениха и устроили свадьбу, глядя друг на друга через мониторы.
В Роскосмосе такой поступок не одобрили, так как имеющий доступ к гостайне Маленченко должен был получить разрешение на брак с гражданкой другого государства в установленном порядке на земле, однако впоследствии он ещё не раз участвовал в космических экспедициях.

Ракеты и космические аппараты с почти всех космодромов в мире запускаются на восток, по направлению вращения Земли. Только израильтяне делают запуски на запад, затрачивая дополнительное горючее.
Дело в том, что с востока Израиль окружён недружелюбными государствами, падение ступеней ракет на территорию которых может спровоцировать военный конфликт. А если ракета летит на запад, ступени падают в Средиземное море.

Спутники Юпитера называют в честь мифологических персонажей, связанных c богом Юпитером или соответствующим ему Зевсом, причём самые крупные спутники носят имена его возлюбленных.
Согласно мифам, Зевс окутал себя облаками, чтобы скрыть прелюбодеяния, однако его жена Гера, она же Юнона, все равно увидела их с Олимпа. Подразумевая этот сюжет, НАСА в 2011 году отправило к Юпитеру автоматическую исследовательскую станцию «Юнона».

Советский аппарат для исследования Луны «Луноход-2» проработал пять месяцев в 1973 году и с тех пор находится в состоянии покоя.
Его возвращение на Землю никогда не подразумевалось и не предполагается теперь.
Это не помешало НПО имени Лавочкина продать «Луноход-2» в 1993 году на аукционе. Покупателем стал американец Ричард Гэрриот, сын астронавта, который и сам впоследствии летал на МКС в качестве туриста.

Бактерия Tersicoccus phoenicis была обнаружена в 2013 году в помещениях, где меньше всего её ожидали найти — стерильных комнатах НАСА и Европейского космического агентства.
Причём между собой они никак не связаны: одна находится во Флориде, там собирался космический аппарат «Феникс», а другая — на космодроме Куру в Южной Америке.
В таких помещениях поддерживается избыточное давление воздуха, их очищают сильнейшими химикатами и ультрафиолетом, но бактериям эти условия вполне подходят.
Возможно, они уже попали на Марс на «Фениксе» или каком-нибудь другом аппарате.

Единственным человеком, чьи мысли покинули Солнечную систему, является продюсер и популяризатор науки Энн Друян, вдова Карла Сагана.
Часовая запись её мозговых волн была включена в золотые пластинки, отправленные с аппаратами «Вояджер-1» и «Вояджер-2».
Во время сеанса считывания Друян старалась думать об истории нашей планеты и развитии жизни на ней, о человеческом обществе, его проблемах, насилии и бедности, а в самом конце позволила себе поразмышлять о любви.


3 февраля 2006 года космонавты МКС вручную запустили экспериментальный спутник SuitSat с радиопередатчиком.
Оболочкой спутника стал списанный скафандр «Орлан», так что внешнему наблюдателю запуск мог бы показаться внештатной ситуацией вылетания космонавта со станции.
SuitSat транслировал голосовые сообщения членов экипажа МКС, а также студентов со всего мира. Он вошёл в земную атмосферу в сентябре того же года.

После крушения шаттла «Колумбия» с семью астронавтами на борту в 2003 году учёные обнаружили среди обломков металлический контейнер с выжившими нематодами вида Caenorhabditis elegans.
Некоторые потомки этих червей были доставлены в 2011 году шаттлом «Индевор» на МКС и стали участниками новых экспериментов.

В 1950-е годы основным средством связи у военных с отдалёнными объектами были радиоволны, отражающиеся от ионосферы Земли.
Чтобы повысить надёжность связи, американцы захотели дополнить её искусственной ионосферой и вывели на среднюю околоземную орбиту 480 миллионов медных иголок длиной около 2 см.
Радиосигналы стали мощнее, однако большого развития это направление не получило из-за появления спутниковой связи, а также из-за протестов учёных, заявивших о недопустимости загрязнения космоса.
Через несколько лет большинство игл сгорело в атмосфере планеты, однако некоторые их скопления продолжают находиться на орбите и по сей день.

Чарльз Пит Конрад ростом 169 см был одним из самых низких астронавтов в истории.
Будучи командиром второй лунной миссии «Аполлон-12», он первым из команды спустился на поверхность спутника.
Иронизируя над своим ростом и знаменитыми словами Нила Армстронга про маленький шаг для него и гигантский скачок для всего человечества, Конрад произнёс свою первую фразу: «Ого! Может быть, он маленький для Нила, но большой для меня».

В Международной космической станции изначально были запланированы американский и российский сегменты, но для американских и европейских астронавтов владение русским языком не было обязательным.
В 2003 году произошла катастрофа шаттла «Колумбия», и с 2011 года НАСА полностью прекратило эксплуатацию космических челноков, после чего полёты астронавтов стали возможны только на российских космических аппаратах «Союз».
В связи с этим НАСА и Европейское космическое агентство включили в программы по подготовке кандидатов курсы русского языка.
Успешная сдача итогового теста стала одним из условий завершения обучения астронавтов, а те из них, кого отбирают для реального полёта на МКС, обязательно живут продолжительное время в российской семье.

Космонавты не могут плакать так же, как мы на земле — выделяющиеся слёзы не стекают вниз, а остаются на глазах в виде маленьких шариков.
К тому же они могут вызывать неприятное жжение, и слёзы приходится смахивать вручную.
Получается, что плач как один из видов психологической разгрузки недоступен человеку в невесомости.

Американские астронавты на космических кораблях серии Аполлон справляли малую нужду в контейнеры, надевающиеся наподобие презервативов.
Эти изделия были спроектированы разных размеров, изначально названных «маленький», «средний» и «большой».
Однако после того, как астронавты независимо от своей анатомии выбирали только большой размер, маркировка была изменена на «большой», «гигантский» и «невероятный».

В 2002 году студент-астрофизик Тэд Робертс, проходивший практику в НАСА, вместе со своей девушкой и ещё двумя сообщниками похитил сейф с лунным грунтом и камнями из всех экспедиций программы «Аполлон».
После ограбления молодые люди поселились в отеле, где Тэд с возлюбленной разложили камни на кровати и прямо на них занялись сексом.
Когда они попытались продать камни через интернет одному коллекционеру, тот связался с ФБР, и в итоге похитители были арестованы и осуждены.

В 1962 году американцы запустили первый космический аппарат для изучения Венеры Маринер-1, потерпевший аварию через несколько минут после старта. Сначала на аппарате отказала антенна, которая получала сигнал от наводящей системы с Земли, после чего управление взял на себя бортовой компьютер. Он тоже не смог исправить отклонение от курса, так как загруженная в него программа содержала единственную ошибку — при переносе инструкций в код для перфокарт в одном из уравнений была пропущена чёрточка над буквой, отсутствие которой коренным образом поменяло математический смысл уравнения.
Журналисты вскоре окрестили эту чёрточку «самым дорогим дефисом в истории» (в пересчёте на сегодняшний день стоимость утерянного аппарата составляет 135 000 000 $).

17 июля 1975 года состоялась стыковка советского космического корабля «Союз» и американского «Аполлон».
Было запланировано, что в момент стыковки корабли должны были пролетать над Москвой, но расчёты оказались не совсем верны, и космонавты обменялись рукопожатием, пролетая над рекой Эльбой.
Символично, что за 30 лет до этого на Эльбе состоялась встреча советских и американских солдат, союзников во Второй Мировой войне.

Члены экипажа корабля Аполлон-11 Нил Армстронг, Базз Олдрин и Майкл Коллинз после возвращения с Луны были вынуждены проходить таможенный осмотр.
В графе отправления таможенного бланка так и было написано — Луна, в графе прибытия — Гонолулу, Гавайи. Был задекларирован и груз — лунные камни и лунная пыль.

Российский космонавт Сергей Крикалёв провёл на орбите в общей сложности 803 дня, что является мировым рекордом.
Одновременно его можно считать обладателем другого рекорда — самого продолжительного путешествия во времени среди жителей нашей планеты. Согласно теории относительности, чем больше скорость, с которой движется объект, тем сильнее для него замедляется время.
Рассчитано, что благодаря космическим полётам Крикалёв на 1/48 секунды моложе, чем если бы он оставался всё время на Земле. Другими словами, космонавт вернулся с орбиты во временную точку на 1/48 секунды позже ожидаемого при нормальных условиях значения.

Космический челнок шаттл был разработан НАСА в конце 1970-х годов и оснащён передовой на то время микропроцессорной техникой, включая процессор Intel 8086.
В 2002 году агентство столкнулось с серьёзной проблемой — нужно было произвести масштабную замену комплектующих согласно нормам их старения на наземном оборудовании по обслуживанию шаттлов, но Intel подобные процессоры уже не производил.
Поэтому их, а также устаревшие материнские платы и восьмидюймовые флоппи-дисководы НАСА было вынуждено покупать в интернете, в основном через аукцион eBay.

Советские беспилотные спутники «Космос» начали запускаться с 1962 года и нумеровались по возрастающей.
Порядковый номер спутника совпал с номером года 10 января 1989 — на орбиту был отправлен «Космос-1989».
В этот же день умер главный конструктор космических систем Валентин Петрович Глушко.

Когда в 1950-х годах было принято решение строить космодром в казахских степях, для введения вероятного противника в заблуждение построили ещё один космодром — деревянный — в посёлке Байконур Карагандинской области.
После старта корабля «Восток-1» с Гагариным на борту это название в печати перешло к настоящему космодрому, находящемуся в 300 км от этого посёлка.

Существует памятник, установленный на Луне. Это алюминиевая фигурка в скафандре, посвящённая памяти космонавтов, которые уже погибли.
На табличке рядом с фигуркой перечислены имена 14-ти погибших, включая Юрия Гагарина.
Памятник установил экипаж Аполлона-15 в 1971 году.

Многоцелевые модули снабжения для МКС названы в честь итальянских деятелей Возрождения: «Леонардо», «Рафаэль» и «Донателло».
Они периодически доставляют на станцию необходимое научное оборудование и другие грузы.
Несмотря на официальную версию названия, на логотипе проекта, нанесённом на каждый модуль, изображён Черепашка-ниндзя в скафандре.


Обратный отсчёт, который неизменно сопровождает запуск космических ракет, был придуман не учёными и не космонавтами, а кинематографистами.
Впервые обратный отсчёт был показан в немецком фильме «Женщина на луне» 1929 года для нагнетания напряжения. Впоследствии при запуске настоящих ракет конструкторы просто переняли этот приём.

В 1999 году аппарат НАСА Mars Climate Orbiter прилетел к Марсу. Однако вместо расчётных 140 он прошёл над поверхностью планеты на высоте всего 57 км и просто сгорел в атмосфере. Позже установили причину аварии: одна группа специалистов при расчётах использовала британские единицы измерения (фунт-сила), а другая — метрические (ньютон).

В 1984 году в СССР был разработан лазерный пистолет несмертельного действия.
Он предназначался для самообороны космонавтов.
Поражающее действие этого пистолета заключалось в выведении из строя чувствительных элементов оптических систем, в том числе глаз человека. А важным преимуществом по сравнению с обычным пистолетом в условиях невесомости было отсутствие отдачи.
Сейчас лазерный пистолет является памятником науки и техники и экспонируется в Музее истории военной академии РВСН.

В 2002 году Германия совместно с США запустила систему из двух космических спутников для измерения гравитации Земли под названием GRACE. Они летают по одной орбите на высоте около 450 километров один за другим, с промежутком 220 километров.
Когда первый спутник подлетает к области с повышенной гравитацией, например, большому горному массиву, он ускоряется и удаляется от второго спутника. А через некоторое время сюда долетает и второй аппарат, тоже ускоряется и тем самым восстанавливает исходную дистанцию.
За подобную игру в «догонялки» спутникам дали имена Том и Джерри.

Первыми животными, возвратившимися на Землю живыми после полёта в космос, были, как известно, собаки.
А вот первенство в облёте Луны принадлежит черепахам. Это случилось в 1968 году: в советский космический корабль Зонд-5 посадили среднеазиатских степных черепах.
Выбор был обоснован тем, что им не требуется большого запаса кислорода, они могут полторы недели ничего не есть и длительное время находиться как бы в летаргическом сне.

Собаку Лайку отправили в космос, заранее зная, что она погибнет.
После этого в ООН пришло письмо от группы женщин из штата Миссисипи. Они потребовали осудить бесчеловечное отношение к собакам в СССР и выдвинули предложение: если для развития науки необходимо посылать в космос живых существ, в нашем городе для этого есть сколько угодно негритят.

(Источник: Лауринчюкас А. Третья сторона доллара. — М., 1968, стр. 27.)
После гибели трёх космонавтов корабля «Союз-11» экипаж «Союза-12» был сокращён до двух человек.
Перед стартом они посмотрели фильм «Белое солнце пустыни», а после удачной миссии говорили, что товарищ Сухов стал незримым третьим членом экипажа и помогал им в трудные минуты.
С тех пор просмотр этой ленты стал традицией для всех советских, а затем и российских космонавтов. Ритуалу нашли и практическое применение: на примерах из фильма космонавтов учат работе с камерой и построению плана съёмки.

На Международной космической станции есть колокол. В него бьют каждый раз, когда происходит смена командира.

В 1960-70-х годах в СССР разрабатывалась авиационно-космическая система «Спираль», состоящая из орбитального самолёта, который должен был выводиться в космос гиперзвуковым самолётом-разгонщиком, а затем ракетной ступенью на орбиту.
Для испытаний был сконструирован аналог орбитального самолёта, оборудованный шасси с лыжно-тарельчатыми опорами.
Однажды во время испытаний тяги двигателей было недостаточно, чтобы сдвинуть с места эти лыжи по грунтовой полосе.
Было решено пригнать два грузовика с арбузами, которые равномерно разбили на протяжении 70 метров. Это обеспечило необходимое скольжение и самолёт сумел тронуться с места и разогнаться.



Сталь для американских спутников, измеряющих космическую радиацию, пришлось добывать из затопленного в 1919 году корабля «Кронпринц Вильгельм», поскольку радиационный фон от стали, изготовленной после 1945 года, слишком велик.

В резьбе кафедрального собора города Саламанка (Испания), построенном в 12 веке, можно обнаружить фигуру космонавта в скафандре. Никакой мистики здесь нет: фигура была добавлена в 1992 году при реставрации одним из мастеров в качестве подписи (он выбрал космонавта как символ 20 века).

Во время подготовки запуска советской автоматической станции к одной из планет возникли проблемы с излишком веса исследовательской аппаратуры. Королёв, изучив чертежи, захотел проверить прибор, который должен был сообщить по радио о наличии или отсутствии органической жизни на планете. Прибор был вывезен в выжженную степь недалеко от космодрома, а затем передал, что жизни на Земле нет, что и послужило причиной его исключения из миссии.

Космонавты Ляхов и Рюмин тайно пронесли в карманах скафандров на орбиту огурец и апельсин. И в первом репортаже показали этот огурец, якобы выросший в станционной оранжерее, хотя до этого растение даже завязи не давало.
Потом космонавты признались в шутке, показав и апельсин.

6 декабря 1957 года, через два месяца после запуска первого в истории советского спутника, американцы попытались запустить свой аппарат Vanguard TV3. Через две секунды после старта ракета взорвалась.
Эта неудача была жёстко раскритикована американскими газетами, придумавшими для аппарата множество неологизмов на основе слова «спутник», включая «упсник» и «капутник».
А спустя несколько дней советский представитель в ООН участливо поинтересовался у американского коллеги, не нуждаются ли США в гуманитарной помощи, выделяемой СССР для неразвитых стран.
Кадры кинохроники запечатлели встречу Гагарина после первого космического полёта в Москве, а больше всего многим запомнился его развязавшийся шнурок. На самом деле эта тесёмка была отцепившейся подтяжкой для носков, которые раньше делали без резинки.
Из-за сползшего носка Гагарина по ноге больно била пряжка, но он не остановился и дошагал по дорожке до конца.

Космонавт Юрий Маленченко незадолго до полёта на МКС в 2003 году сделал предложение американке российского происхождения Екатерине Дмитриевой, мать которой работала в НАСА.
Находясь на станции, он получил уведомление из Центра управления полётами, что его миссия продлевается на несколько месяцев. Молодожёны решили не дожидаться возвращения жениха и устроили свадьбу, глядя друг на друга через мониторы.
В Роскосмосе такой поступок не одобрили, так как имеющий доступ к гостайне Маленченко должен был получить разрешение на брак с гражданкой другого государства в установленном порядке на земле, однако впоследствии он ещё не раз участвовал в космических экспедициях.

Ракеты и космические аппараты с почти всех космодромов в мире запускаются на восток, по направлению вращения Земли. Только израильтяне делают запуски на запад, затрачивая дополнительное горючее.
Дело в том, что с востока Израиль окружён недружелюбными государствами, падение ступеней ракет на территорию которых может спровоцировать военный конфликт. А если ракета летит на запад, ступени падают в Средиземное море.

Спутники Юпитера называют в честь мифологических персонажей, связанных c богом Юпитером или соответствующим ему Зевсом, причём самые крупные спутники носят имена его возлюбленных.
Согласно мифам, Зевс окутал себя облаками, чтобы скрыть прелюбодеяния, однако его жена Гера, она же Юнона, все равно увидела их с Олимпа. Подразумевая этот сюжет, НАСА в 2011 году отправило к Юпитеру автоматическую исследовательскую станцию «Юнона».

Советский аппарат для исследования Луны «Луноход-2» проработал пять месяцев в 1973 году и с тех пор находится в состоянии покоя.
Его возвращение на Землю никогда не подразумевалось и не предполагается теперь.
Это не помешало НПО имени Лавочкина продать «Луноход-2» в 1993 году на аукционе. Покупателем стал американец Ричард Гэрриот, сын астронавта, который и сам впоследствии летал на МКС в качестве туриста.

Бактерия Tersicoccus phoenicis была обнаружена в 2013 году в помещениях, где меньше всего её ожидали найти — стерильных комнатах НАСА и Европейского космического агентства.
Причём между собой они никак не связаны: одна находится во Флориде, там собирался космический аппарат «Феникс», а другая — на космодроме Куру в Южной Америке.
В таких помещениях поддерживается избыточное давление воздуха, их очищают сильнейшими химикатами и ультрафиолетом, но бактериям эти условия вполне подходят.
Возможно, они уже попали на Марс на «Фениксе» или каком-нибудь другом аппарате.
Единственным человеком, чьи мысли покинули Солнечную систему, является продюсер и популяризатор науки Энн Друян, вдова Карла Сагана.
Часовая запись её мозговых волн была включена в золотые пластинки, отправленные с аппаратами «Вояджер-1» и «Вояджер-2».
Во время сеанса считывания Друян старалась думать об истории нашей планеты и развитии жизни на ней, о человеческом обществе, его проблемах, насилии и бедности, а в самом конце позволила себе поразмышлять о любви.


3 февраля 2006 года космонавты МКС вручную запустили экспериментальный спутник SuitSat с радиопередатчиком.
Оболочкой спутника стал списанный скафандр «Орлан», так что внешнему наблюдателю запуск мог бы показаться внештатной ситуацией вылетания космонавта со станции.
SuitSat транслировал голосовые сообщения членов экипажа МКС, а также студентов со всего мира. Он вошёл в земную атмосферу в сентябре того же года.

После крушения шаттла «Колумбия» с семью астронавтами на борту в 2003 году учёные обнаружили среди обломков металлический контейнер с выжившими нематодами вида Caenorhabditis elegans.
Некоторые потомки этих червей были доставлены в 2011 году шаттлом «Индевор» на МКС и стали участниками новых экспериментов.

В 1950-е годы основным средством связи у военных с отдалёнными объектами были радиоволны, отражающиеся от ионосферы Земли.
Чтобы повысить надёжность связи, американцы захотели дополнить её искусственной ионосферой и вывели на среднюю околоземную орбиту 480 миллионов медных иголок длиной около 2 см.
Радиосигналы стали мощнее, однако большого развития это направление не получило из-за появления спутниковой связи, а также из-за протестов учёных, заявивших о недопустимости загрязнения космоса.
Через несколько лет большинство игл сгорело в атмосфере планеты, однако некоторые их скопления продолжают находиться на орбите и по сей день.

Чарльз Пит Конрад ростом 169 см был одним из самых низких астронавтов в истории.
Будучи командиром второй лунной миссии «Аполлон-12», он первым из команды спустился на поверхность спутника.
Иронизируя над своим ростом и знаменитыми словами Нила Армстронга про маленький шаг для него и гигантский скачок для всего человечества, Конрад произнёс свою первую фразу: «Ого! Может быть, он маленький для Нила, но большой для меня».

В Международной космической станции изначально были запланированы американский и российский сегменты, но для американских и европейских астронавтов владение русским языком не было обязательным.
В 2003 году произошла катастрофа шаттла «Колумбия», и с 2011 года НАСА полностью прекратило эксплуатацию космических челноков, после чего полёты астронавтов стали возможны только на российских космических аппаратах «Союз».
В связи с этим НАСА и Европейское космическое агентство включили в программы по подготовке кандидатов курсы русского языка.
Успешная сдача итогового теста стала одним из условий завершения обучения астронавтов, а те из них, кого отбирают для реального полёта на МКС, обязательно живут продолжительное время в российской семье.

Космонавты не могут плакать так же, как мы на земле — выделяющиеся слёзы не стекают вниз, а остаются на глазах в виде маленьких шариков.
К тому же они могут вызывать неприятное жжение, и слёзы приходится смахивать вручную.
Получается, что плач как один из видов психологической разгрузки недоступен человеку в невесомости.

Американские астронавты на космических кораблях серии Аполлон справляли малую нужду в контейнеры, надевающиеся наподобие презервативов.
Эти изделия были спроектированы разных размеров, изначально названных «маленький», «средний» и «большой».
Однако после того, как астронавты независимо от своей анатомии выбирали только большой размер, маркировка была изменена на «большой», «гигантский» и «невероятный».

В 2002 году студент-астрофизик Тэд Робертс, проходивший практику в НАСА, вместе со своей девушкой и ещё двумя сообщниками похитил сейф с лунным грунтом и камнями из всех экспедиций программы «Аполлон».
После ограбления молодые люди поселились в отеле, где Тэд с возлюбленной разложили камни на кровати и прямо на них занялись сексом.
Когда они попытались продать камни через интернет одному коллекционеру, тот связался с ФБР, и в итоге похитители были арестованы и осуждены.

В 1962 году американцы запустили первый космический аппарат для изучения Венеры Маринер-1, потерпевший аварию через несколько минут после старта. Сначала на аппарате отказала антенна, которая получала сигнал от наводящей системы с Земли, после чего управление взял на себя бортовой компьютер. Он тоже не смог исправить отклонение от курса, так как загруженная в него программа содержала единственную ошибку — при переносе инструкций в код для перфокарт в одном из уравнений была пропущена чёрточка над буквой, отсутствие которой коренным образом поменяло математический смысл уравнения.
Журналисты вскоре окрестили эту чёрточку «самым дорогим дефисом в истории» (в пересчёте на сегодняшний день стоимость утерянного аппарата составляет 135 000 000 $).

17 июля 1975 года состоялась стыковка советского космического корабля «Союз» и американского «Аполлон».
Было запланировано, что в момент стыковки корабли должны были пролетать над Москвой, но расчёты оказались не совсем верны, и космонавты обменялись рукопожатием, пролетая над рекой Эльбой.
Символично, что за 30 лет до этого на Эльбе состоялась встреча советских и американских солдат, союзников во Второй Мировой войне.

Члены экипажа корабля Аполлон-11 Нил Армстронг, Базз Олдрин и Майкл Коллинз после возвращения с Луны были вынуждены проходить таможенный осмотр.
В графе отправления таможенного бланка так и было написано — Луна, в графе прибытия — Гонолулу, Гавайи. Был задекларирован и груз — лунные камни и лунная пыль.

Российский космонавт Сергей Крикалёв провёл на орбите в общей сложности 803 дня, что является мировым рекордом.
Одновременно его можно считать обладателем другого рекорда — самого продолжительного путешествия во времени среди жителей нашей планеты. Согласно теории относительности, чем больше скорость, с которой движется объект, тем сильнее для него замедляется время.
Рассчитано, что благодаря космическим полётам Крикалёв на 1/48 секунды моложе, чем если бы он оставался всё время на Земле. Другими словами, космонавт вернулся с орбиты во временную точку на 1/48 секунды позже ожидаемого при нормальных условиях значения.

Космический челнок шаттл был разработан НАСА в конце 1970-х годов и оснащён передовой на то время микропроцессорной техникой, включая процессор Intel 8086.
В 2002 году агентство столкнулось с серьёзной проблемой — нужно было произвести масштабную замену комплектующих согласно нормам их старения на наземном оборудовании по обслуживанию шаттлов, но Intel подобные процессоры уже не производил.
Поэтому их, а также устаревшие материнские платы и восьмидюймовые флоппи-дисководы НАСА было вынуждено покупать в интернете, в основном через аукцион eBay.

Советские беспилотные спутники «Космос» начали запускаться с 1962 года и нумеровались по возрастающей.
Порядковый номер спутника совпал с номером года 10 января 1989 — на орбиту был отправлен «Космос-1989».
В этот же день умер главный конструктор космических систем Валентин Петрович Глушко.

Когда в 1950-х годах было принято решение строить космодром в казахских степях, для введения вероятного противника в заблуждение построили ещё один космодром — деревянный — в посёлке Байконур Карагандинской области.
После старта корабля «Восток-1» с Гагариным на борту это название в печати перешло к настоящему космодрому, находящемуся в 300 км от этого посёлка.

Существует памятник, установленный на Луне. Это алюминиевая фигурка в скафандре, посвящённая памяти космонавтов, которые уже погибли.
На табличке рядом с фигуркой перечислены имена 14-ти погибших, включая Юрия Гагарина.
Памятник установил экипаж Аполлона-15 в 1971 году.

Многоцелевые модули снабжения для МКС названы в честь итальянских деятелей Возрождения: «Леонардо», «Рафаэль» и «Донателло».
Они периодически доставляют на станцию необходимое научное оборудование и другие грузы.
Несмотря на официальную версию названия, на логотипе проекта, нанесённом на каждый модуль, изображён Черепашка-ниндзя в скафандре.


Обратный отсчёт, который неизменно сопровождает запуск космических ракет, был придуман не учёными и не космонавтами, а кинематографистами.
Впервые обратный отсчёт был показан в немецком фильме «Женщина на луне» 1929 года для нагнетания напряжения. Впоследствии при запуске настоящих ракет конструкторы просто переняли этот приём.

В 1999 году аппарат НАСА Mars Climate Orbiter прилетел к Марсу. Однако вместо расчётных 140 он прошёл над поверхностью планеты на высоте всего 57 км и просто сгорел в атмосфере. Позже установили причину аварии: одна группа специалистов при расчётах использовала британские единицы измерения (фунт-сила), а другая — метрические (ньютон).

В 1984 году в СССР был разработан лазерный пистолет несмертельного действия.
Он предназначался для самообороны космонавтов.
Поражающее действие этого пистолета заключалось в выведении из строя чувствительных элементов оптических систем, в том числе глаз человека. А важным преимуществом по сравнению с обычным пистолетом в условиях невесомости было отсутствие отдачи.
Сейчас лазерный пистолет является памятником науки и техники и экспонируется в Музее истории военной академии РВСН.

В 2002 году Германия совместно с США запустила систему из двух космических спутников для измерения гравитации Земли под названием GRACE. Они летают по одной орбите на высоте около 450 километров один за другим, с промежутком 220 километров.
Когда первый спутник подлетает к области с повышенной гравитацией, например, большому горному массиву, он ускоряется и удаляется от второго спутника. А через некоторое время сюда долетает и второй аппарат, тоже ускоряется и тем самым восстанавливает исходную дистанцию.
За подобную игру в «догонялки» спутникам дали имена Том и Джерри.

Первыми животными, возвратившимися на Землю живыми после полёта в космос, были, как известно, собаки.
А вот первенство в облёте Луны принадлежит черепахам. Это случилось в 1968 году: в советский космический корабль Зонд-5 посадили среднеазиатских степных черепах.
Выбор был обоснован тем, что им не требуется большого запаса кислорода, они могут полторы недели ничего не есть и длительное время находиться как бы в летаргическом сне.

Собаку Лайку отправили в космос, заранее зная, что она погибнет.
После этого в ООН пришло письмо от группы женщин из штата Миссисипи. Они потребовали осудить бесчеловечное отношение к собакам в СССР и выдвинули предложение: если для развития науки необходимо посылать в космос живых существ, в нашем городе для этого есть сколько угодно негритят.

(Источник: Лауринчюкас А. Третья сторона доллара. — М., 1968, стр. 27.)
После гибели трёх космонавтов корабля «Союз-11» экипаж «Союза-12» был сокращён до двух человек.
Перед стартом они посмотрели фильм «Белое солнце пустыни», а после удачной миссии говорили, что товарищ Сухов стал незримым третьим членом экипажа и помогал им в трудные минуты.
С тех пор просмотр этой ленты стал традицией для всех советских, а затем и российских космонавтов. Ритуалу нашли и практическое применение: на примерах из фильма космонавтов учат работе с камерой и построению плана съёмки.

На Международной космической станции есть колокол. В него бьют каждый раз, когда происходит смена командира.

В 1960-70-х годах в СССР разрабатывалась авиационно-космическая система «Спираль», состоящая из орбитального самолёта, который должен был выводиться в космос гиперзвуковым самолётом-разгонщиком, а затем ракетной ступенью на орбиту.
Для испытаний был сконструирован аналог орбитального самолёта, оборудованный шасси с лыжно-тарельчатыми опорами.
Однажды во время испытаний тяги двигателей было недостаточно, чтобы сдвинуть с места эти лыжи по грунтовой полосе.
Было решено пригнать два грузовика с арбузами, которые равномерно разбили на протяжении 70 метров. Это обеспечило необходимое скольжение и самолёт сумел тронуться с места и разогнаться.



Сталь для американских спутников, измеряющих космическую радиацию, пришлось добывать из затопленного в 1919 году корабля «Кронпринц Вильгельм», поскольку радиационный фон от стали, изготовленной после 1945 года, слишком велик.

В резьбе кафедрального собора города Саламанка (Испания), построенном в 12 веке, можно обнаружить фигуру космонавта в скафандре. Никакой мистики здесь нет: фигура была добавлена в 1992 году при реставрации одним из мастеров в качестве подписи (он выбрал космонавта как символ 20 века).

Во время подготовки запуска советской автоматической станции к одной из планет возникли проблемы с излишком веса исследовательской аппаратуры. Королёв, изучив чертежи, захотел проверить прибор, который должен был сообщить по радио о наличии или отсутствии органической жизни на планете. Прибор был вывезен в выжженную степь недалеко от космодрома, а затем передал, что жизни на Земле нет, что и послужило причиной его исключения из миссии.

Космонавты Ляхов и Рюмин тайно пронесли в карманах скафандров на орбиту огурец и апельсин. И в первом репортаже показали этот огурец, якобы выросший в станционной оранжерее, хотя до этого растение даже завязи не давало.
Потом космонавты признались в шутке, показав и апельсин.

6 декабря 1957 года, через два месяца после запуска первого в истории советского спутника, американцы попытались запустить свой аппарат Vanguard TV3. Через две секунды после старта ракета взорвалась.
Эта неудача была жёстко раскритикована американскими газетами, придумавшими для аппарата множество неологизмов на основе слова «спутник», включая «упсник» и «капутник».
А спустя несколько дней советский представитель в ООН участливо поинтересовался у американского коллеги, не нуждаются ли США в гуманитарной помощи, выделяемой СССР для неразвитых стран.
Только зарегистрированные и авторизованные пользователи могут оставлять комментарии.
0
Любопытно!
- ↓
-2
Все это пиз… шь чистой воды… особенно про негритят… две.держав(одна колония убившея индейцев и живущая на их земле и продолжающая их-индейцев-притеснять) пытались миру показать кто круче-в итоге высадка на луну-пизде… ь \\слов нет… ну о «марсе ваще молчек»…
- ↓
+5
Познавательно!
- ↓
+2
У Гагарина шнурки развязаны были и это было отчетливо видно на кадрах кинохроники.
- ↓

